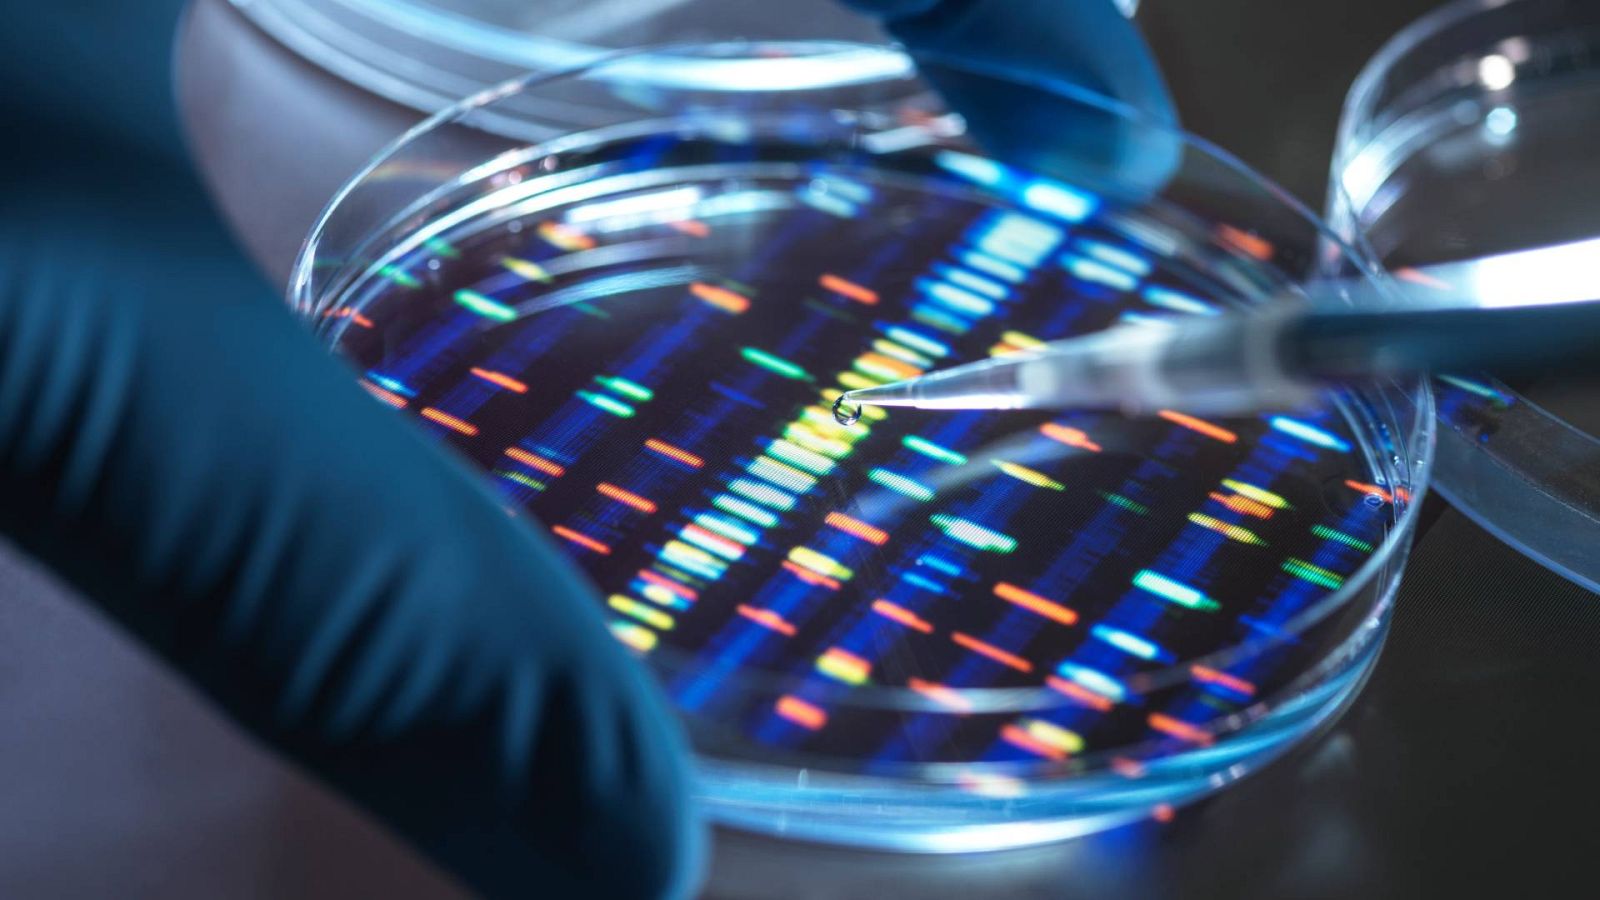
A este tipo de vacunas se les conoce como "terapéuticas", ya que no se emplean de manera preventiva.

Cuenta atrás para la primera vacuna de ARN mensajero contra el cáncer: "Salvará cientos de miles, si no millones de vidas"
- Los primeros resultados son muy prometedores: combinada con inmunoterapia, reduce la mortalidad del melanoma en un 44%
- Podría estar lista antes de 2030, según Moderna, que también prepara vacunas contra otros tumores y enfermedades

La farmacéutica Moderna cree que su vacuna personalizada contra el melanoma, basada en ARN mensajero, podría estar lista para finales de esta década. Aunque aún se encuentra en fase clínica, los resultados son esperanzadores, ya que según los datos de su ensayo en fase 2, esta vacuna experimental, en combinación con la inmunoterapia, consigue reducir en un 44% el riesgo de recaída o muerte del cáncer de piel más letal. Desde la compañía estadounidense aseguran que están trabajando para desarrollar otras vacunas, también basadas en ARN mensajero, para combatir todo tipo de tumores, además de enfermedades raras, autoinmunes y cardiovasculares.
"Tendremos esa vacuna y será muy eficaz, y salvará muchos cientos de miles, si no millones de vidas. Creo que podremos ofrecer vacunas personalizadas contra múltiples tipos de tumores a personas de todo el mundo", ha asegurado el director médico de Moderna, Paul Burton, en declaraciones al periódico británico The Guardian.
A este tipo de vacunas se les conoce como "terapéuticas", ya que no se emplean de manera preventiva, sino para combatir de manera más eficiente el cáncer cuando este ya se ha desarrollado. Sin embargo, la estrategia es similar a la de cualquier vacuna: inducir una respuesta del sistema inmunológico. En este caso, la mediada por células inmunitarias específicas contra células cancerosas, con el objetivo de revertir los tumores malignos.
"Nosotros estamos acostumbrados a vacunas para enfermedades infecciosas, y de forma preventiva. Aquí lo que se hace es un estímulo del sistema inmune para que, en este caso concreto junto con el resto de tratamientos que se aplican contra el cáncer, pueda ayudar a vencer esta enfermedad", declara a RTVE.es Jaime Jesús Pérez, presidente de la Asociación Española de Vacunología, quien define al cáncer como "una patología que en el fondo es un fallo que se produce en nuestro organismo, en cuanto que primero hay una mutación, y después el sistema inmune no la reconoce o consigue escapar de este, con lo que crece".
La vacuna de Moderna se basa en la tecnología de ARN mensajero, la misma que ha sido empleada con éxito contra la enfermedad COVID-19. De hecho, ambas guardan una estrecha relación. "La razón por la que la tecnología de ARN mensajero estaba tan avanzada cuando surgió el COVID es porque se llevaba mucho tiempo trabajando en ella con vistas a utilizarla como inmunoterapia contra el cáncer", explica a RTVE.es Matilde Cañelles, inmunóloga del CSIC.
En este sentido, Jaime Jesús Pérez asegura que "la tecnología de ARN mensajero la hemos conocido por las enfermedades infecciosas, pero aproximadamente el 80% de sus desarrollos no están relacionados con enfermedades infecciosas".
Impedir el crecimiento de tumores
A diferencia de la vacuna contra el coronavirus, la misión en el caso del cáncer es alertar al sistema inmunitario de un tumor que ya está creciendo dentro de un paciente para que pueda atacarlo y destruirlo, conservando intactas las células sanas. Para ello, se identifican proteínas en la superficie de las células cancerosas que no están presentes en las células sanas, y luego se crean fragmentos de ARN mensajero que indicarán al organismo cómo fabricar estas proteínas asociadas a tumores, para que el sistema inmunitario aprenda a reconocerlas y atacarlas.
La vacuna de ARN mensajero contra el melanoma se diseña de manera personalizada, lo que aumenta las probabilidades de éxito del tratamiento y al mismo tiempo reduce su toxicidad. Para conseguirlo, los médicos toman una biopsia del tumor del paciente y la envían al laboratorio, donde se secuencia este material genético para identificar las mutaciones que no están presentes en las células sanas. Después, se identifican las mutaciones responsables del crecimiento del cáncer, así como las proteínas que codifican estas mutaciones y cuáles de ellas tienen más probabilidades de desencadenar una respuesta inmunitaria. Finalmente, se fabrican los fragmentos de ARN mensajero con las instrucciones para producir estos antígenos y se empaquetan en una vacuna personalizada.
Para aumentar su eficacia, la vacuna experimental de Moderna se aplica en combinación con 'Keytruda' (pembrolizuma), un anticuerpo monoclonal desarrollado por la farmacéutica MSD, que ya lleva tiempo en el mercado.
A pesar de que califica los resultados como "muy prometedores", Matilde Cañelles pide cautela a la hora de recibir estos datos aportados por Moderna. "Ni siquiera es un preprint, es una comunicación de la propia farmacéutica que ha hecho en un congreso científico, presentando resultados de la fase 2 de su ensayo clínico, que se hace con muy pocos pacientes. Por ejemplo, ahora sabemos que hay muchas vacunas COVID que han pasado la fase 2, pero no han superado la fase 3", advierte, y recuerda que "aún queda que supere la fase 3 y después recibir la aceptación de las agencias reguladoras".
Además, esta inmunóloga ve otro inconveniente importante, asociado al hecho de que "estamos hablando de medicina personalizada". "Este ARN mensajero lo hacen en base a las células de cada paciente. No es como la vacuna contra el COVID, que a todo el mundo se le pone la misma. Así que en el momento en el que se comercialice, comenzará teniendo un precio muy alto, porque no es algo que se pueda producir en masa", prevé.

Letrero de la farmacéutica Moderna en su sede de Cambridge, Estados Unidos. BRIAN SNYDER / REUTERS
Designación de "terapia innovadora"
En febrero, la Administración de Alimentos y Medicamentos de Estados Unidos (FDA, por sus siglas en inglés) concedió la designación de "terapia innovadora" a esta vacuna contra el cáncer de Moderna para pacientes con melanoma, con el objetivo de acelerar su desarrollo y revisión. La decisión de Estados Unidos se produjo dos meses después de que Moderna presentara sus resultados provisionales del ensayo clínico en fase 2.
Moderna y MSD tienen previsto discutir estos datos con las autoridades reguladoras e iniciar un estudio de fase 3 en melanoma antes de que finalice 2023. Además, planean ampliarlo "rápidamente" a otras patologías, ya que "puede aplicarse a todo tipo de enfermedades: cáncer, enfermedades infecciosas, cardiovasculares, autoinmunes y raras. Tenemos estudios en todas esas áreas y todos han demostrado ser tremendamente prometedores", resalta Paul Burton, de Moderna.
Sobre su potencialidad para combatir las enfermedades raras -solo en España unos tres millones de personas las padecen-, la tecnología de ARN mensajero es aún más prometedora, si cabe. "Creo que tendremos terapias basadas en el ARN mensajero para enfermedades raras que antes no se podían curar, y que dentro de 10 años nos acercaremos a un mundo en el que realmente se podrá identificar la causa genética de una enfermedad y, con relativa sencillez, editarla y repararla utilizando tecnología basada en el ARN mensajero", declara Burton.
La tecnología de ARN mensajero comienza a dar las primeras muestras de su gran potencial, aunque aún le queda mucho camino por recorrer, y también que demostrar, a la altura de las elevadas expectativas que ha depositado en ella una comunidad científica que también es consciente de sus limitaciones. "Yo creo que va a ser revolucionaria. Tampoco va a ser la panacea que va a resolver todos los problemas, pero es muy poderosa y pienso que va a suponer una revolución en la medicina, porque nos va a permitir hacer cosas que antes teníamos completamente vetadas, como en el caso concreto del melanoma, que se consigue reducir la mortalidad a la mitad", valora en este sentido la inmunóloga Matilde Cañelles.
El vacunólogo Jaime Jesús Pérez opina al respecto que "es una plataforma más" y pide "ser un poco escépticos". "Es verdad que su rapidez y versatilidad son muy importantes, y eso hace que sea especialmente atractiva, pero también es cierto que la tecnología en sí misma tampoco es el bálsamo de Fierabrás, no lo va a solucionar todo", indica.
"Inmunológicamente se comporta muy bien, porque provoca una respuesta del sistema inmune tanto humoral como celular. Pero eso no significa que todas las vacunas que están por descubrir vayan a venir con esta tecnología, afortunadamente va a haber muchas más plataformas", asegura.



